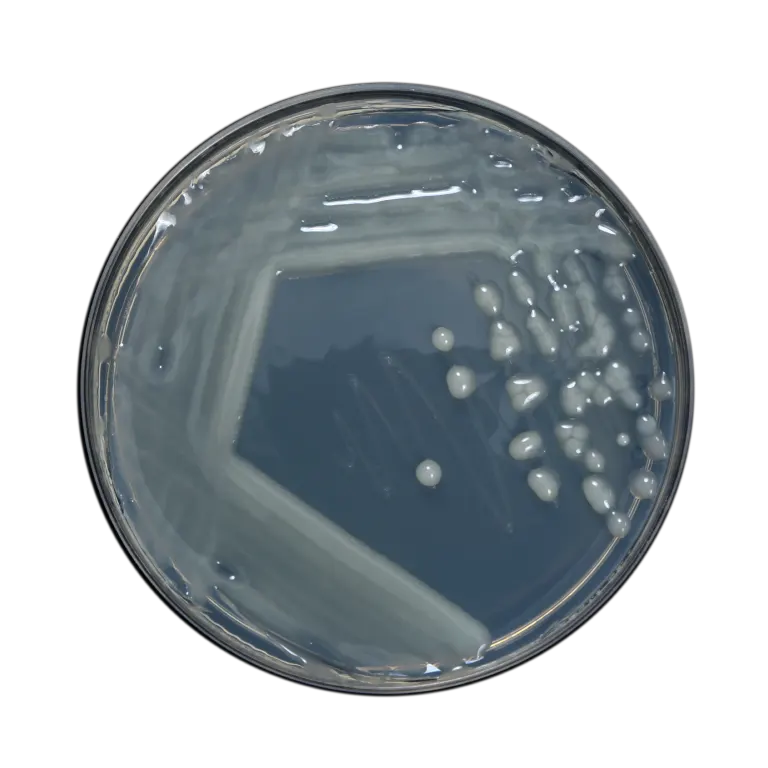
product
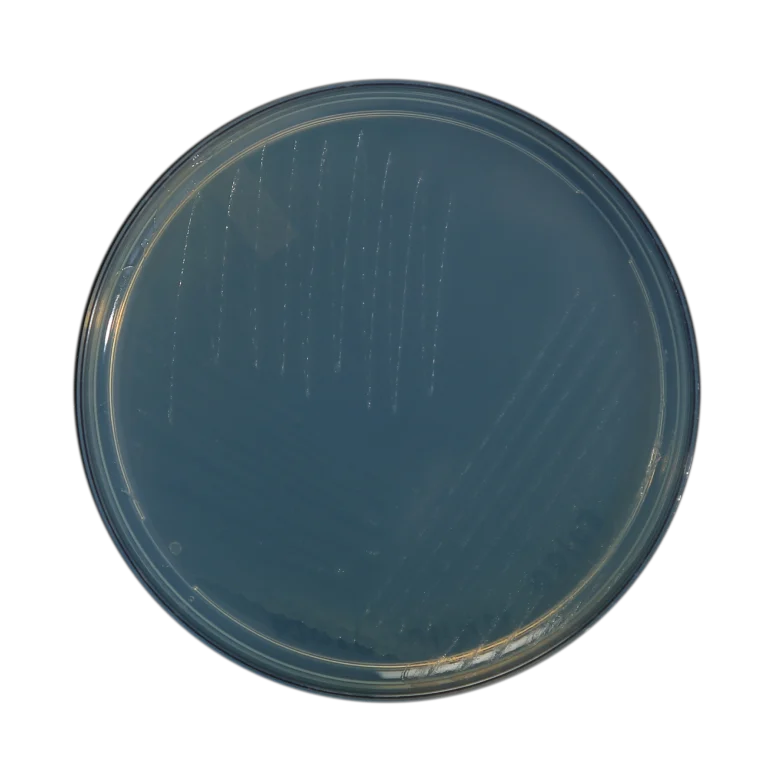
product
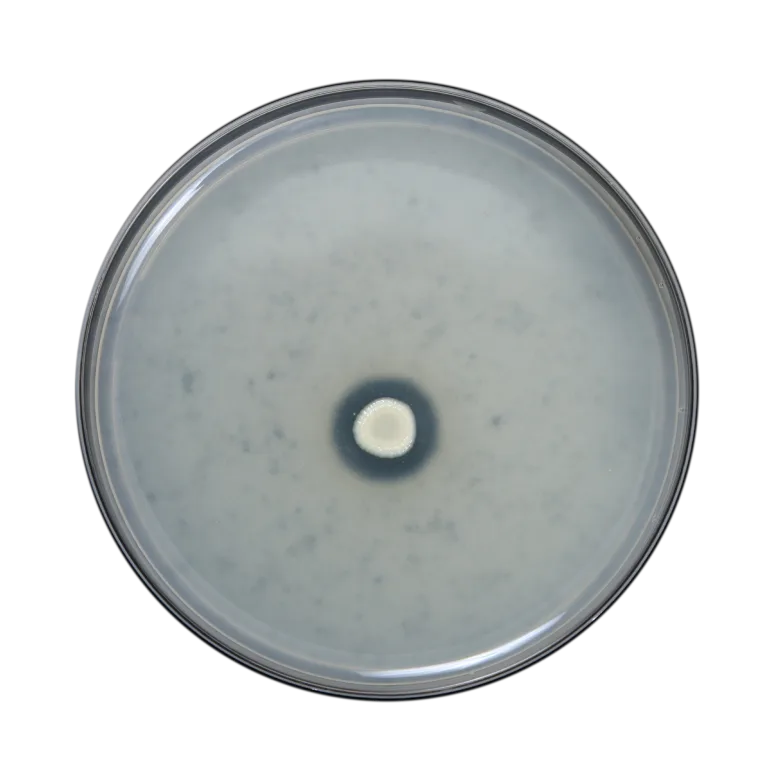
product
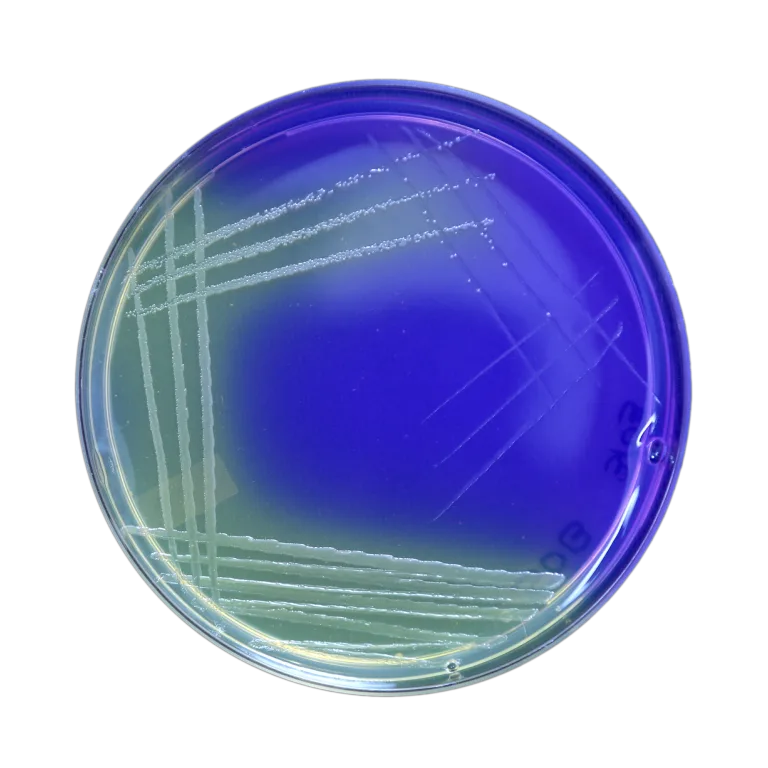
product

Bio Fertilizer Liquid

Azospirillum
A self-sustaining nitrogen-binding microorganism closely linked with grasses. Azospirillum Microbe…
Learn More
Phosphate Solubilizing Bacteria
Phosphorus is the second most crucial mineral nutrient that often…
Learn More
Potassium Mobilizing Bacteria
This bacterium aids in mobilizing the insoluble potassium form for…
Learn More

Phosphate Solubilizing Fungal
They are a set of advantageous microbes capable of breaking…
Learn More
Sulphur Oxidizing Bacteria
Sulphur oxidizers participate in the conversion of elemental sulfur into…
Learn More
Calcium Solubilizing Bacteria
Calcium-solubilizing microorganisms are beneficial organisms that transform insoluble calcium into…
Learn More